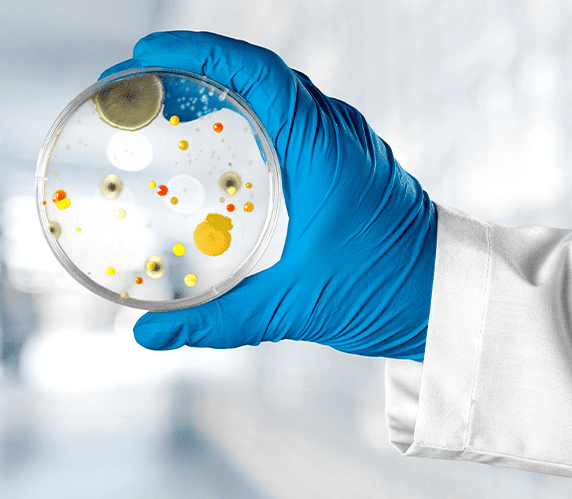

Biocare Diagnostics’ IVD Division delivers reliable, advanced diagnostic solutions that support accurate and timely clinical decisions. Our portfolio includes clinical chemistry, immunoassays, hematology, rapid tests, and molecular diagnostics.In partnership with global technology leaders, we bring high-quality, innovative tools to hospitals, labs, and point-of-care settings enhancing disease detection and improving patient outcomes.

We deliver advanced biochemistry automation systems and high-quality reagents tailored for today’s clinical laboratories. Our solutions ensure precision, speed, and scalability—reducing manual effort and enhancing diagnostic accuracy In collaboration with leading global partners.

We offers advanced hematology systems designed for modern labs. Our range includes:
3-Part Analyzers for reliable routine CBC testing
5-Part Analyzers for detailed WBC differentials
Flow Cytometry Platforms for advanced cell analysis and clinical precision

We offer cutting-edge immunology solutions powered by CLIA (Chemiluminescence Immunoassay) technology. Designed for accuracy, sensitivity, and speed, our systems support early diagnosis and effective disease management across a broad range of parameters.
With reliable instruments and high-quality reagents, our solutions ensure consistent performance, operational efficiency, and ease of use in modern laboratory environments.
Biocare Diagnostics offers end-to-end Microbiology Laboratory Setup Solutions, including equipment, consumables, and workflow planning.

Biocare Diagnostics provides comprehensive solutions in clinical pathology, including automated urine and stool analyzers for enhanced diagnostic efficiency and precision.
We also offer Liquid-Based Cytology (LBC) solutions for improved sample quality, accurate cytological evaluations, and early disease detection, supporting advanced screening in histopathology and gynecology.

Biocare Diagnostics offers a comprehensive range of IVD quality control materials to ensure accuracy, reliability, and compliance in laboratory testing across clinical chemistry, immunology, hematology, and molecular diagnostics.
We’re here to help. Reach out to our team for inquiries, support, or collaboration opportunities. Let’s connect and make diagnostics better together.